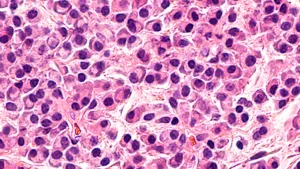
Ilustrační obrázek

Reportáže a rozhovory z odborných kongresů

Reportáže a rozhovory z odborných kongresů
Opouštíte prostředí společnosti Pfizer, spol. s r. o.
Společnost Pfizer, spol. s r. o., neručí za obsah stránek, které hodláte navštívit.
Přejete si pokračovat?